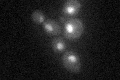
YMR075W
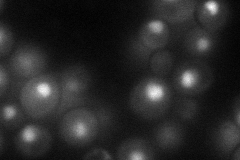
YMR075W
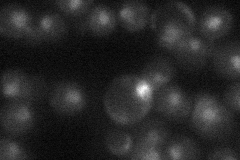
YMR075W
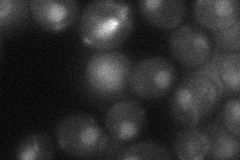
YMR075W
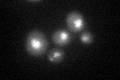
YMR075W
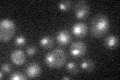
YMR075W

View description
Essential subunit of the histone deacetylase Rpd3S complex; interacts with Eaf3p
Localization:
Intensity:
Fold change:
Significance:
-
C’ GFP library in SD
nucleus22.74 -
N' NOP1pr-GFP in SD
nucleus61.6488 -
N' TEF2pr-mCherry in SD

nucleus37.5031 -
N' NATIVEpr-GFP in SD
nucleus26.9303 -
N' TEF2pr-VC and Cyto-VN in SD
nucleus30.055 -
C’ GFP library in SD+DTT
nucleus25.471.12No -
C’ GFP library in SD+H2O2

nucleus27.551.21No -
C’ GFP library in Starvation Media
nucleus20.630.9No -
C’ GFP library on the background of Pup2-DaMP

nucleus -
C’ GFP library on the background of CCT mutant

nucleus22.53210.990802No
